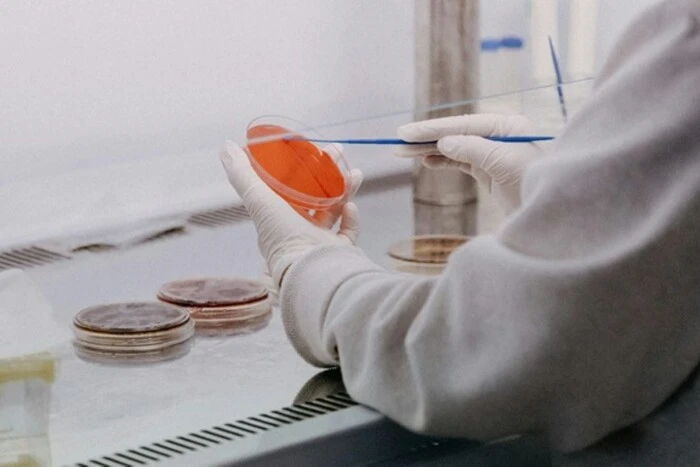

В одному з дитсадків на Дарниці зафіксовано спалах гострої кишкової інфекції
Фахівці розпочали епідеміологічне розслідування для з’ясування джерела та причин спалаху
У Києві зареєстрували чотири випадки гострої кишкової інфекції серед вихованців одного з дошкільних навчальних закладів Дарницького району. Про це повідомили у Київському міському центрі контролю та профілактики хвороб, інформує «Главком».
Повідомляється, що усі хворі 26 травня були госпіталізовані до медичних установ столиці та проходять бактеріологічне обстеження на кишкову групу інфекцій. Фахівці розпочали епідеміологічне розслідування для з’ясування джерела та причин спалаху.
Симптоми гострих кишкових інфекцій:
- слабкість,
- підвищення температури,
- біль у животі,
- блювота і діарея.
Профілактика гострих кишкових інфекцій:
- Підтримуйте чистоту: мийте руки перед тим, як брати продукти чи готувати їжу. Також мийте руки після відвідування туалету, дезінфікуйте всі поверхні та кухонне приладдя, які використовуєте для приготування їжі. Захищайте кухню і продукти від комах, гризунів та інших тварин.
- Відокремлюйте сиру їжу від готової: варто відмежовувати сире м’ясо і морепродукти від інших харчових продуктів. Для обробки сирих продуктів користуйтеся окремим кухонним приладдям, зокрема ножами і обробними дошками. Зберігайте продукти у закритому посуді, щоб уникнути контакту між сирими та готовими продуктами.
- Ретельно готуйте їжу: ретельно просмажуйте чи проварюйте продукти, особливо м’ясо, яйця і морепродукти. Доводьте страви до кипіння, щоб вони готувалися щонайменше за 70 °C, сік м’яса чи птиці під час приготування має бути прозорим, а не рожевим. Також ретельно підігрівайте приготовану їжу.
- Зберігайте їжу при безпечній температурі: не залишайте приготовану їжу за кімнатної температури більш ніж на 2 години. Зберігайте приготовані страви гарячими (60 °C) аж до подавання до столу. Не варто зберігати їжу надто довго, навіть у холодильнику та не розморожуйте продукти за кімнатної температури.
- Використовуйте безпечну воду і свіжі продукти: вживайте чисту або очищену воду. Обирайте свіжі та незіпсовані продукти, які потрібно ретельно мити, особливо якщо вживатимете їх сирими. Не їжте продукти, у яких закінчився термін придатності.
Нагадаємо, тиждень тому у Дніпровському районі Києва було зареєстровано чотири випадки гострої кишкової інфекції серед вихованців одного з дошкільних навчальних закладів.
















Коментарі — 0